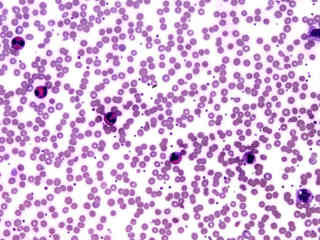

Home ⇨ Blood cells under microscope labeled
Blood Cells Under Microscope Labeled
Download Blood cells under microscope labeled For Android Free - Check out this fantastic collection of Best HD wallpapers, with the Best HD background images for your desktop, phone or tablet. Today i will share Blood cells under microscope labeled wallpaper. Download wallpapers for desktop free. High Quality HD pictures wallpapers.


Get Blood cells under microscope labeled HD















/white_blood_cells-581115905f9b58564c7a051a-5c45e6c04cedfd0001877a06.jpg)

/red_blood_cells_1-57b20c583df78cd39c2f8e15.jpg)

:background_color(FFFFFF):format(jpeg)/images/library/13191/histology-blood_english.jpg)

















